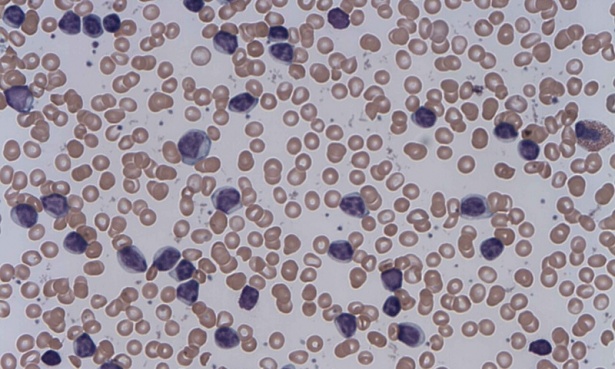

Хронична лимфоцитна левкемия МКБ C91.1
В групата на лимфоидните левкемии се включва и хронична лимфоцитна левкемия.
Представлява моноклонално заболяване, с прогресивно натрупване на функционално незрели лимфоцити в кръвта и костния мозък и бавна еволюция.
По произход клетките са клонални В лимфоцити, прекъснали своята диференциация между пре-В клетките и зрелите В клетки. Морфологично в периферната кръв тези клетки наподобяват зрели лимфоцити, но са имунологично непълноценни.
Патологичните клетки експресират изключително ниски нива на имуноглобулини и леки вериги.
Състоянието се среща много рядко в Азия, засяга по-често бялата раса, с доминиране на мъжкия пол във възрастта след 60 години.
При повечето пациенти се наблюдава анормален кариотип, като най-честата аномалия е делеция на късото рамо на хромозома 13. При малък процент от случаите се наблюдава тризомия 12 или делеция на късото рамо на хромозома 17. Тези аномалии са свързани с бърза прогресия на заболяването, краткотрайна ремисия и намалена обща преживяемост.
Доказана е свръхекспресия на прото-онкогена bcl2, който потиска апоптозата и така води до по-дълъг живот на засегнатите клетки.
Идентифицирани са редица високо рискови генетични фактори и маркери, като повишена CD38 експресия, увеличени нива на серумните бета2 имуноглобулини, повишена серумна тимидин киназа. Наличието им се асоциира с резистентност към лечението и неблагоприятна прогноза.
Заболяването се характеризира с дълго безсимптомно протичане и бавен ход. Често се открива случайно при изследване по повод на друго заболяване или при профилактични прегледи.
Възможно е изява на някои от следните признаци:
- отпадналост и лесна уморяемост
- нощни изпотявания
- намален апетит
- редукция на телесното тегло
- увеличени лимфни възли
- спленомегалия
- чести рецидивиращи инфекции
Засегнатите лимфни възли са неболезнени и с меко еластична консистенция. Поради нарушения клетъчен имунитет и непълноценните В лимфоцити, често се наблюдават пулмонални инфекции.
Диагнозата на хронична лимфоцитна левкемия се основава на множеството проведени клинико-лабраторни и образни изследвания. При физикалния преглед най-често се установява периферна лимфаденопатия и спленомегалия.
Лабораторните данни показват силно изразена левкоцитоза, анемия и тромбоцитопения. Често се установява хипогамаглобулинемия чрез имунологични изследвания, а с помощта на биопсия на костен мозък се доказват характерните промени и инфилтрация с непълноценни клетки.
Рутинно се извършва ехография, която обикновено показва спленомегалия или хепатомегалия.
Категоризирането на заболяването се извършва чрез две различни системи. Системата на Rai-Sawitsky разделя този тип левкемия според риска на:
- нисък риск: наблюдава се лимфоцитоза в кръвта и костния мозък
- среден риск: лимфоцитоза, в комбинация с увеличени лимфни възли или спленомегалия
- висок риск: лимфоцитоза, в съчетание с предизвикана от болестта анемия и/или тромбоцитопения
Системата на Binet разделя заболяването, в зависимост от броя на засегнатите групи лимфни възли:
- стадий А: стабилно ниво на хемоглобина и тромбоцитите и ангажиране на по-малко от три групи лимфни възли
- стадий В: стабилни нива на хемоглобин и тромбоцити, засягане на повече от три групи лимфни възли
- стадий С: изключително ниски нива на хемоглобин и/или тромбоцити
Лечение се налага само при напредналите стадии на заболяването, докато при началните етапи се препоръчва редовно проследяване на пациентите и симптоматична терапия.
Лечението се състои в комбинирана полихимиотерапия, като някои от най-често използваните схеми са следните:
- FCR: комбинация от флударабин, циклофосфамид и ритуксимаб
- CVP: комбинация от циклофосфамид, винкристин и преднизон
- CHOP: съдържа циклофосфамид, доксорубицин, винкристин и преднизон
При пациенти с рецидивиращи инфекции се прилага и заместваща терапия с гама-глобулин.
Прогнозата и преживяемостта при отделните пациенти с хронична лимфоцитна левкемия варира в широки граници и зависи основно от стадия на заболяването, терапевтичния отговор, възрастта и състоянието на болния.
Заглавно изображение: Erhabor Osaro (Associate Professor), CC BY-SA 3.0, via Wikimedia Commons
Симптоми и признаци при Хронична лимфоцитна левкемия МКБ C91.1
- Умора
- Безсимптомно протичане на заболявания
- Повишена телесна температура
- Недостиг на въздух (диспнея)
- Загуба на тегло
- Загуба на апетит

Коментари към Хронична лимфоцитна левкемия МКБ C91.1
Пламена
Здравейте, при направена кръвна картина с стойност на лимфоцити 50, при горна граница 40 има ли възможност за левкемия? Благодаря предварително за отговора
Здравейте! Повишени нива на лимфоцити (лимфоцитоза) могат да се наблюдават също така при вирусни или бактериални инфекции.
Имайте предвид, че самостоятелното тълкуване на даден кръвен показател не позволява поставяне/отхвърляне на диагноза. Необходимо е да се консултирате с лекаря, назначил това изследване, който чрез подробно снета анамнеза, физикално изследване и при необходимост допълнителни изследвания ще установи причината за отклоненията в стойностите на лимфоцитите.
Здравейте, при направена кръвна картина с стойност на лимфоцити 50, при горна граница 40 има ли възможност за левкемия? Благодаря предварително за отговора